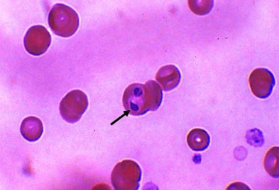
knowt flashcard image

Clin path - Cestodes, Trematodes, Protozoa
0.0(0)
Studied by 0 peopleCard Sorting
1/15
There's no tags or description
Looks like no tags are added yet.
Last updated 6:07 PM on 3/30/26
Name | Mastery | Learn | Test | Matching | Spaced | Call with Kai |
|---|
No analytics yet
Send a link to your students to track their progress
16 Terms
1
New cards
Tritrichomonas foetus

2
New cards
Giardia

3
New cards
Toxoplasma gondii

4
New cards
Babesia Canis
5
New cards
Dipylidum Caninum
Most common
Dogs and cats

6
New cards
Pseudiphyllidean

7
New cards
Pyriform

8
New cards
Taenia taeniaeformis
Cats tapeworm

9
New cards
Taenia Multiceps
Dog tapeworm

10
New cards
Echinococcus granulosus
Dogs

11
New cards
Echinococcus mulilocularis
Dogs and cats

12
New cards
Platynosomun Fastosum

13
New cards
Nanophyetus Salmincola

14
New cards
Alaria

15
New cards
Cryptosporidium

16
New cards